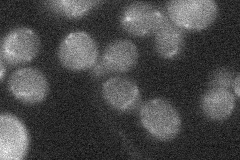
YLL012W

View description
Steryl ester hydrolase, one of three gene products (Yeh1p, Yeh2p, Tgl1p) responsible for steryl ester hydrolase activity and involved in sterol homeostasis; localized to lipid particle membranes
Localization:
Intensity:
Fold change:
Significance:
-
C’ GFP library in SD

below threshold17.34 -
N' NOP1pr-GFP in SD

punctate22.2881 -
N' TEF2pr-mCherry in SD

below threshold6.56321 -
N' NATIVEpr-GFP in SD
below threshold18.5647 -
N' TEF2pr-VC and Cyto-VN in SD

#N/A0 -
C’ GFP library in SD+DTT

cytosol15.670.9No -
C’ GFP library in SD+H2O2

cytosol17.551.01No -
C’ GFP library in Starvation Media

cytosol14.530.83No -
C’ GFP library on the background of Pup2-DaMP

N/A -
C’ GFP library on the background of CCT mutant

N/A0N/AYes
